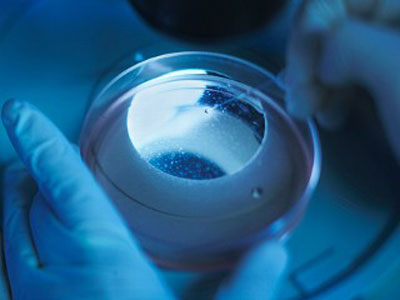
2.jpg

1. Xây dựng
thành công bản đồ hệ gen người

Năm 2000, các nhà
khoa học trong Dự án Hệ gen người quốc tế đã công bố phác thảo về toàn
bộ các
gen ở người và đăng tải trên internet. Lần đầu tiên, cả thế giới có thể
download và đọc một cách đầy đủ nhất thông tin vào toàn bộ gen người.
Bản đồ gen người
đã được đầu tư thời gian và tiền bạc từ những năm 90 của thế kỷ 20 với 2
nhóm
thực hiện: Dự án Hệ gen người do chính phủ tài trợ, dự kiến hoàn thành
trong 10
năm với số tiền lên tới 2,5 tỉ đô la và công ty Celera Genomics chi hơn
100
triệu đô la trong gần 1 thập kỷ để thực hiện nghiên cứu độc lập này.
Cả 2 nhóm đều
cùng công bố phác thảo về hệ gen người vào 26/6/2000 tại cuộc họp báo
với sự tham
dự của Tổng thống Bill Clinton và Thủ tướng Anh Tony Blair. “Đó là một
bước
ngoặt lớn tương tự như sự kiện con người bước đi trên mặt trăng”, TS
Francis
Collins, Giám đốc Viện nghiên cứu Gen người quốc gia cho biết khi bản đồ
gen
được hoàn thành.
Năm 2004, phác
thảo “cuối cùng” đã được công bố bởi các nhà nghiên cứu và năm 2007, đã
có sự bổ
sung bởi TS Craig Venter, giám đốc khoa học công ty Celera Genomics.
Với việc xây dựng
thành công bản đồ hệ gen người, chúng ta có quyền tin vào tương lai với
những
loại thuốc và những liệu pháp mới hiệu quả và ít độc với cơ thể người
hơn.
2. Sự
ngoạn mục trong nghiên cứu tế bào gốc
Có lẽ chưa có
lĩnh vực nào kích thích trí tưởng tượng và khơi gợi sự tranh luận trong
cộng đồng
như việc nghiên cứu tế bào gốc.
Mặc dù bị vướng
phải những lệnh cấm nhưng những tiến bộ trong nghiên cứu tế bào gốc là
không thể
phủ nhận. Ví như các nhà nghiên cứu châu Âu đã tách các tế bào tủy xương
từ 2
cậu bé 7 tuổi và rồi cấy tế bào đã được biến đổi vào cơ thể 2 cậu bé này
để
điều trị bệnh ALD (bệnh liên quan đến não gọi là liên kết giới tính X).
Nhà nghiên cứu tế
bào gốc TS George Daley của bệnh viện Nhi Boston gọi quá trình nghiên
cứu tế bào
gốc ở cả phôi thai và người trưởng thành trong thập kỷ này là sự “ngoạn
mục”.
Mới đây nhất, các
nhà khoa học Trung Quốc đã tạo ra 1 con chuột từ những tế bào da và điều
này cho
thấy khoa học trong thập kỷ qua đã thực sự tạo ra được điều kỳ diệu và
chúng ta
có quyền hy vọng trong thập kỷ mới này sẽ có những phương pháp điều trị
mới sử dụng tế bào gốc.
3. Liệu pháp
thuốc phối hợp trong điều trị AIDS

Kể từ khi xuất
hiện liệu pháp điều trị kháng retroviral hoạt tính cao (HAART) năm 1996,
HIV không
còn là một căn bệnh chết người mà trở thành 1 căn bệnh mãn tính với cơ
hội sống
kéo dài tới vài thập kỷ.
Hơn thế, phương
pháp “pha trộn tổng hợp” này cũng trở thành một mô hình điều trị các
bệnh khác,
từ ung thư phổi đến ung thư tim.
Trong suốt 1 thập
kỷ qua, các nhà nghiên cứu vẫn không ngừng tinh lọc phương pháp này để
nâng cao
hiệu quả điều trị. Nhờ đó, tỉ lệ tử vong do HIV đã giảm trên toàn thế
giới.
4. Kỹ thuật
xâm nhập tối thiểu – Cuộc cách mạng trong phẫu thuật

Cách đây 10 năm,
cứ phẫu thuật nội tạng là để lại một vết sẹo dài tới 15cm nhưng công
nghệ phẫu
thuật mới – kỹ thuật xâm nhập tối thiểu – đã giúp người bệnh thoát khỏi
nỗi ám
ảnh từ các vết sẹo khủng khiếp này.
Vào cuối những
năm 2000, các bác sĩ ở Bệnh viện Cleverland đã bắt đầu áp dụng kỹ thuật
này trong
việc lấy 1 quả thận đường rốn trong một ca phẫu thuật ghép thận. Ngày
nay, kỹ
thuật này được áp dụng nhiều trong các phẫu thuật tử cung, buồng trứng.
Các bác sĩ phẫu
thuật cũng sử dụng các rô-bốt để tăng độ chính xác của các thao tác khi
phẫu thuật.
Điều này đã giúp rút ngắn thời gian nằm điều trị, giảm những nguy cơ sức
khỏe
do mổ mở, người bệnh nhanh phục hồi.
5. Phát minh
ra máy ghi hình cộng hưởng từ (MRI)

“Đọc vị” bộ óc
qua từng chi tiết ở các mô mềm, nghiên cứu hoạt động của não bộ khi con
người
suy nghĩ, làm việc, nói; xác định những vùng liên hệ đến ý thức, trí
nhớ, nghe
nhạc, đọc sách, lái xe…; chỉ rõ các điểm bất thường liên hệ nhiều xáo
trộn thần
kinh, MRI thực sự là một cuộc cách mạng trong y học.
Ra đời vào đầu
những năm 90 của thế kỷ trước nhưng mãi tới năm 2003, phát minh này mới
được thế
giới công nhận và được trao giải Nobel. Uỷ ban Nobel ghi nhận đã có
22.000 MRI
được sử dụng trên toàn cầu với hơn 60 triệu lần khám trong vào năm 2002
và nhấn
mạnh tính vô hại vì không dùng tia X.
Với việc sử dụng
công nghệ này, các nhà nghiên cứu hiện đã biết thêm nhiều thông tin giá
trị về
các bệnh như trầm cảm, ung thư não, tự kỷ, rối loạn trí nhớ và thậm chí
là cả
các bệnh ngoài da.
Nhân Hà
dantri.com.vn

